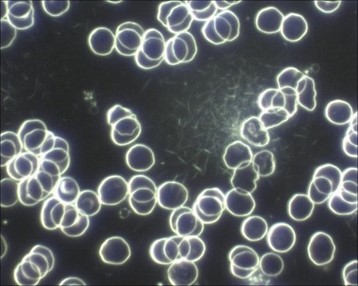

Als Thrombose bezeichnet man einen vollständigen oder teilweisen Verschluss von Blutgefäßen durch ein Blutgerinnsel (=Blutkoagel; Thrombus).
INHALTSVERZEICHNIS
Dieser Verschluss kann sowohl im arteriellen, als auch im venösen Bereich der Gefäße erfolgen. Das Resultat ist immer ein verminderter Blutfluss bis hin zum Blutstau, sollte der Thrombus so groß sein, dass er das Gefäß völlig verstopft.
Die Basis der Thrombenbildung ist eine körperliche Schutzfunktion, die in diesem Fall außer Kontrolle geraten ist. Denn bei einer Verletzung der Blutgefäße benutzt der Organismus Thrombozyten und Fibrin, um damit einen „Blutklumpen“ (Thrombus) zu kreieren, der das Loch im Gefäß verstopft und somit einen nachhaltigen Blutverlust verhindert. Gerät dieses Notfallsystem außer Kontrolle, dann können auch Thromben entstehen, ohne dass eine Verletzung der Gefäßwände vorliegt.
Ein an die Gefäßwand angelagerter Thrombus verengt das Lumen des betroffenen Gefäßes, je nach Größe des Thrombus. Ein Thrombus, der sich loslöst von der Gefäßwand, wandert durch das Blutgefäßsystem des gesamten Körpers. Löst er sich nicht rechtzeitig auf, dann kann er als Embolus eine Embolie zum Beispiel in der Lunge auslösen oder einen Infarkt in den Herzkranzgefäßen.
So können Thrombosen in allen Gefäßen entstehen. Die häufigsten Formen sind Thrombosen in den Venen und speziell in den tiefen Beinvenen. Arterielle Thrombosen sind ebenfalls möglich, aber deutlich seltener:

Abb. 1: Ablagerungen und Verengungen in einem Gefäß (hier eine grafische Darstellung). Vor der Engstelle könnte sich bereits ein Thrombus gebildet haben. Bildquelle: fotolia.com – man_at_mouse
Ursachen
Die Schulmedizin kennt im Wesentlichen drei Ursachen, die sie als „Virchow-Trias“ bezeichnet. Diese Trias besteht aus:
- Veränderungen der Viskosität des Bluts, was heißt, dass das Blut „dicker“ wird und somit schlechter fließen kann.
- Veränderungen der Strömungsgeschwindigkeit des Bluts, was erklärt, dass Gerinnsel immer da auftreten, wo die Strömungsgeschwindigkeit herabgesetzt ist und Turbulenzen entstehen.
- Schäden an der Gefäßwand als Ursache der Bildung von Gerinnseln.
Obwohl dieser „Ursachenkatalog“ Virchow-Trias genannt wird, ist er nie von Virchow selbst aufgestellt worden, sondern erst lange nach seinem Tod. Aber das tut ja hier nichts zur Sache (eigentlich).
Ein Vergleich mit einer modernen Version dieser Trias zeigt, dass die historische Version immer noch in der Schulmedizin einiges an Geltung genießt. Die Virchow-Trias und die moderne Trias beschreiben beide die Thrombose. Die Virchow-Trias wurde in der Folge als eine Trias charakterisiert, die die „Konsequenzen einer Thrombose“ beschreibt. Die moderne Trias beschreibt dagegen die „Ursache der Thrombose“.
Und so sieht die moderne Trias aus:
- Hämostase (Blutstau) – Die Veränderungen des Blutflusses können auf verschiedenen Ursachen beruhen, wie zum Beispiel Venenstau, Mitralstenose,
- langfristige Bewegungslosigkeit (wie bei Reisen im Flugzeug und so weiter) und Krampfadern.
- Verletzungen von Gefäßen und Gefäßwand – Hier kommen Verletzungen von Außen ebenso in Frage wie auch Bluthochdruck. Weiter spielen Oberflächenphänomene eine Rolle, wie zum Beispiel der Kontakt mit Materialien, die eine Oberfläche haben, die eine Koagulation initiieren können. Dabei handelt es sich um zum Beispiel Bakterien, kleine Teilchen von Fremdkörpern, Biomaterialien von Implantaten oder Medizingeräten (Defibrillatoren, Herzschrittmachern, Stents, künstliche Gelenke und so weiter), Membranen von aktivierten Thrombozyten und Membranen von Monozyten bei einer chronischen Entzündung.
- Thrombophilie – Eine erhöhte Thromboseneigung. Bei dieser Kategorie spielen eine große Zahl an möglichen Risikofaktoren eine Rolle, die die Aggregationsneigung der Thrombozyten erhöhen kann. Die sind eine erhöhte Viskosität des Bluts, Mangel an Antithrombin III, Protein C oder S Mangel, Leiden V Faktor Mutation, Veränderungen nach einem schweren Trauma oder Verbrennungen, eine weit streuende Krebserkrankung, Schwangerschaft im fortgeschrittenem Alter, Rauchen, Anti-Baby-Pille und Übergewicht.
Klassifikation und Symptome
Prinzipiell lassen sich die Thrombosen in zwei übergeordnete Klassen aufteilen: venöse und arterielle Thrombosen.
Beide Klassen beinhalten mehrere Subtypen, die zumeist auf der entsprechenden Lokalisation beruhen. Die Lage und der Schweregrad dieser Thrombosen bestimmt dann auch die damit verbundenen Symptome. Oft werden überhaupt keine Symptome verspürt. Dies ist der Grund, warum Thrombosen oft sehr spät diagnostiziert werden und zu einem Stadium führen, wo sie Ursache für eine Lungenembolie werden können. Aber werfen wir einmal einen Blick auf die Verschiedenartigkeit der Thrombosen:
Venöse Thromboseformen
Venöse Thrombosen:
Hier liegt ein Thrombus in der Vene vor, meist in den Beinvenen. Eine besondere Form ist die tiefe Venenthrombose, einem Thrombus in den tiefen Venen der Beine, meist der Waden und/oder der Oberschenkelvene (Vena femoralis). Oberflächliche venöse Thrombosen sind oft unangenehm, sind aber in der Regel nicht mit üblen gesundheitlichen Konsequenzen verbunden. Tiefe Venenthrombosen dagegen gelten als mögliche Ursache für das Auftreten von Embolien.
Weil das Blut in den Venen direkt zum rechten Vorhof des Herzens transportiert wird und von hier weitergeleitet wird zur rechten Herzkammer und von hier weiter in die Lunge, kann ein losgelöster Thrombus über diesen Weg mit in die Lunge geschwemmt werden. Verstopft er dann aufgrund einer ausreichenden Größe die Lungenarterien, dann kommt es zu einer Lungenembolie. Eine Lungenembolie ist eine lebensgefährliche Komplikation, die von der Größe des betroffenen Areals beeinflusst wird.
Portale Venenthrombose:
Diese Form der venösen Thrombose betrifft die Pfortader der Leber, auch Portaderthrombose genannt. Ein Verschluss dieser Ader äußert sich entweder gar nicht oder durch Stauphänomene in den angeschlossenen Organen. Das können sein Ösophagusvarizen, Hämorrhoiden, Vergrößerung der Milz, Aszites (Wasseransammlungen in der Bauchhöhle). Die Leberfunktion ist in der Regel stark beeinträchtigt, alldieweil die Blutversorgung der Leber durch die Thrombose nachhaltig gestört ist. Die Ursachen für eine portale Venenthrombose können sein: Pankreatitis, Leberzirrhose, Divertikulitis oder ein Cholangiokarzinom (Karzinom des Gallengangs).
Budd-Chiari-Syndrom:
Es handelt sich hier um eine seltene Lebererkrankung, die auf einem Verschluss der Lebervenen beruht. Die Ursachen sind (wieder einmal) nicht bekannt, oder aber werden durch Thromben verursacht. Tumore können auch Lebervenen so zusammenpressen, dass es zu einem Verschluss der Venen kommt.
Paget-von-Schroetter-Syndrom:
Hierbei handelt es sich um eine Thrombose der tiefen Achselvenen, Armvenen und Schlüsselbeinvenen. Ihr Vorkommen beschränkt sich fast ausschließlich auf junge erwachsene Männer und fast immer auf die rechte Seite. Eine Thrombose in diesem Bereich verläuft meist ohne Symptome oder Schmerzen. Es kann unter Umständen zu Schwellungen des Arms kommen, der sich zudem rot und bläulich verfärbt. Die Oberflächenvenen treten deutlicher hervor, was ein Zeichen ist, dass hier Umgehungsvenen gebildet worden sind. Es kann ein Druckgefühl oder Spannungsgefühl in der Achsel entstehen. Thromben aus dieser Region können auch für die Entstehung einer Lungenembolie verantwortlich sein.
Sinusthrombose:
Diese Form der Thrombose bezeichnet das Auftreten von Thromben in den großen venösen Zusammenflüssen des Gehirns, den venösen Sinus durae matris, also der harten Hirnhaut. Diese Form der Thrombose ist selten, führt aber fast immer zu einem Schlaganfall. Die Ursachen für eine Sinusthrombose können eitrige Infektionen im Gesichtsbereich oder der Nasenhöhlen sein. Mastoiditis oder Meningitis gelten ebenfalls als mögliche Ursache. In diesem Fall wird von einer „septischen Sinusthrombose“ gesprochen.
Andere Ursachen sind Erkrankungen, bei denen eine gesteigerte Blutgerinnung vorliegt, wie Polyzythämie und Antithrombin-Mangel. Anti-Baby-Pille und Kortikosteroide (Cortison) gelten ebenfalls als mögliche Auslöser. Die Symptome sind umfangreich und wenig spezifisch: Kopfschmerzen, epileptische Anfälle, Druckschmerzen im Augenbereich, Sehstörungen, Nackenschmerzen, die bis in die Arme ausstrahlen, Ödeme in den Augenlidern, psychotische Veränderungen, Fieber, Lähmungen, Sehverlust, Schwellungen der Augenbindehaut, Bewusstseinseintrübungen, Gefühlsstörungen, Hirndruck, und im späteren Stadium kann es zum Tode führen.
Nierenvenenthrombose:
Wie die Bezeichnung es schon verrät, handelt es sich hier um eine Thrombose in der Nierenvene (Vena renalis). Symptome sind hier Schmerzen im Nierenbereich, blutiger Urin und so weiter. Als Ursache gelten bestimmte Krebserkrankungen oder ein nephrotisches Syndrom.
Arterielle Thromboseformen
Wie bereits erwähnt tritt bei einer arteriellen Thrombose ein Blutgerinnsel in den Arterien auf. In vielen Fällen stammt ein solcher Thrombus aus einem abgerissenen arteriellen Plaque oder Atherom (nicht zu verwechseln mit Epidermoidzysten oder Talgretentionszysten, die auch Atherome genannt werden). Daher werden solche Thrombosen auch Atherothrombosen genannt.
Eine weitere häufige Ursache für einen arteriellen Verschluss ist Vorhofflimmern (des Herzens). Dieses schnelle Pulsieren des Vorhofs bewirkt eine schlechte Pumpfunktion und somit ein nur schwaches Fließen des Bluts innerhalb des Vorhofs. Das wiederum erhöht die Neigung zur Thrombenbildung signifikant. Inzwischen weiß man auch, dass nach einer Kardioversion durch Elektroschocks nach Vorhofflimmern das Risiko für eine Entstehung eines arteriellen Thrombus signifikant erhöht ist.
Rund 5 Prozent aller Fälle ist davon betroffen, wenn keine gleichzeitige Therapie mit Antikoagulantien erfolgt. Denn nach einer erfolgreichen Wiederherstellung des Sinusrhythmus des Herzens kommt es zu einer Klärung der Thromben im Vorhof, die in die Kammer abwandern und in der Folge ins arterielle System weitergeleitet werden. Ein solcher Thrombus kann einen Infarkt in jedem Organ des Körpers auslösen. Hier ein paar Beispiele dafür:
Schlaganfall:
Durch die Verlegung der Hirnarterien durch einen Thrombus kommt es zu einer Minderdurchblutung oder zu einem totalen Stopp der Durchblutung in Arealen des Gehirns. Die Blockierung erfolgt allerdings allmählich, was zu einem langsamen Einsetzen der Symptome führen kann. Betroffen werden große und kleine Gefäße. Je nach Größe der betroffenen Areale fallen die damit verbundenen Schädigungen aus. Nicht selten nehmen solche Fälle einen tödlichen Ausgang oder führen zu dauerhaften Behinderungen.
Herzinfarkt:
Auch hier liegt in der Regel eine Ischämie vor, die durch eine Verengung der Herzkranzgefäße hervorgerufen wird. Dies kann, muss aber nicht ein Thrombus sein, der die Koronarien der Herzkranzgefäße verengt. Ein „Zuwachsen“ der Gefäße ist ebenso denkbar oder die Kombination beider Prozesse. Ein sich Verengen der Gefäßwände aufgrund von Plaquebildung würde zusätzlich bewirken, dass auch kleinere Thromben schon zu einer Blockade führen und einen Infarkt bewirken.
Andere Bereiche:
Eine Thrombose in den Leberarterien sind meist ernste Komplikationen nach einer Lebertransplantation. Es sind auch arterielle Embolien in den Gliedmaßen beschrieben worden, die aber einen noch höheren Seltenheitswert haben.
Die hier aufgeführten Beispiele und Formen sind nur die wichtigsten und häufigsten Formen. Prinzipiell sind Embolien und Thrombosen in jedem Teil des Körpers möglich, sowohl im venösen, als auch im arteriellen Bereich.
Prävention – Vorbeugung
Prävention gegen Thrombose. Das hört sich hübsch “medizinisch” an. Und wenn man in der Schulmedizin von “Prävention” redet, dann ist der Griff in den Medikamentenschrank nicht weit. Motto: Döschen auf, Pille rein, der Patient wird dann schon glücklich sein.
So gab es auch Ideen, eine medikamentöse Prophylaxe mit Hilfe von Heparin durchzuführen. Allerdings zeigte sich, dass man die Rechnung ohne die Biochemie des Organismus gemacht hatte. Unter der Heparin-Prophylaxe zeigte sich nämlich keine Senkung der Mortalität. Sie senkte zwar die Zahl der Lungenembolien und tiefen Beinvenenthrombosen, aber erhöhte signifikant die Neigung zu lebensbedrohlichen Blutungen (Heparin for the prevention of venous thromboembolism in general medical patients (excluding stroke and myocardial infarction) und Venous thromboembolism prophylaxis in hospitalized medical patients and those with stroke: a background review for an American College of Physicians Clinical Practice Guideline.).
Man glaubt heute, dass nach gewissen Operationen eine prophylaktische Gabe von Heparin eine Reihe von Thrombosen verhindern kann. Aber es handelt sich hier um eine Vermutung und keine evidenzbasierte, abgesicherte Therapie beziehungsweise präventive Maßnahme.
Grund für diese Bemühungen ist die Tatsache, dass Thrombosen häufig in Krankenhäusern entstehen und ein Hauptgrund für Komplikationen darstellen. Daher sind die Bemühungen einer Prophylaxe durchaus verständlich. Bei Patienten nach einer OP werden oft Kompressionsstrümpfe eingesetzt. Bei schweren Erkrankungen, die die Patienten bettlägerig machen, wird eine begleitende Prophylaxe mit niedermolekularem Heparin durchgeführt, mechanische Wadenkompressen oder bei einer tiefen Venenthrombose des Beins ein Cavafilter in der unteren Hohlvene eingeführt, der in der Lage ist, Thromben abzufangen.
Das Hauptproblem bei Heparin und anderen „Blutverdünnern“ ist die erhöhte Blutungsneigung. Grund hierfür ist der Eingriff in die Gerinnungskaskade, was eine genaue, individuelle Dosierung und Monitoring notwendig macht.
Im Gegensatz dazu gibt es einige naturheilkundliche Alternativen, auf die ich weiter unten im Beitrag eingehe.
Eine „exotische“ Form der Prophylaxe bietet der Einsatz von Heilpilzen, speziell Ganoderma (Effect of Ganoderma japonicum (Fr.) Lloyd mixture on experimental thrombosis) – Diese Arbeit zeigte, dass Ganoderma japonicum anti-thrombotisch wirksam ist, ohne in die Biochemie der Gerinnungskaskade einzugreifen. Unter einer Gabe von Ganoderma wurde eine Verringerung eines experimentell erzeugten Thrombus in Gewicht und Größe beobachtet.
Studies on screening, isolation and purification of a fibrinolytic protease from an isolate (VK12) of Ganoderma lucidum and evaluation of its antithrombotic activity – Diese Arbeit zeigte, dass Ganoderma lucidum eine Protease besitzt, die anti-thrombotisch wirksam ist. Die anti-thrombotische Wirkung, so wurde von den Autoren beobachtet, beruhte aber nicht auf einer koagulationshemmenden Wirkung (über den Eingriff in die eben erwähnte Gerinnungskaskade), sondern auf die Thrombozytenaggregation, die durch ADP induziert wird. Die Ganoderma-Protease schützte Mäuse vor einem Tod oder Lähmungen durch Thromboembolien bei einer zugeführten Wirkmenge von nur 60 Mikrogramm pro Kilogramm Körpergewicht. Ähnliche Effekte zeigten sich unter Aspirin in ungleich höheren Konzentrationen von 10 bis 20 Milligramm (nicht Mikrogramm!) pro Kilogramm Körpergewicht.
Experimental and clinical studies on inhibitory effect of ganoderma lucidum on platelet aggregation: Diese Arbeit von 1990 zeigte als eine der ersten Arbeiten, dass Ganoderma in vivo die Thrombozytenaggregation günstig beeinflusst. Auch hier fielen auftretende in vitro Thromben deutlich kleiner und leichter aus als ohne Vorbehandlung mit Ganoderma.
The lack of antiplatelet effect of crude extracts from ganoderma lucidum on HIV-positive hemophiliacs:
Immer wieder warnen die Vertreter der Schulmedizin vor naturheilkundlichen Substanzen, die die Blutgerinnung beeinflussen. Immer wieder werden Horrorszenarien bemüht, die von einer unkontrollierten Blutungsneigung berichten, vor allem in Kombination mit schulmedizinischen Methoden. Dass es diese Szenarien gibt, lässt sich nicht bestreiten. Aber ich möchte bestreiten, dass hier die natürlichen Substanzen als Ursache anzusehen sind und nicht die Medikamente der Schulmedizin.
Von Heparin wissen wir inzwischen, dass eine erhöhte Blutungsneigung besteht, ganz ohne alternativmedizinisches Dazutun. Diese Arbeit von 1990 untersuchte die Blutungsneigung von HIV-positiven Blutern unter der Gabe von Ganoderma – ein wirkliches Horrorszenario für die Bluter. Denn Ganoderma enthält hohe Konzentrationen an Adenosin, was die Gerinnungsneigung herabsetzen hilft. In dieser Arbeit wurden 5 Freiwillige Bluter mit 1,35 Milligramm Adenosin via Ganoderma Extrakt täglich versorgt.
Es wurde ein Thrombozytenaggregationstest vor und nach der Beobachtungszeit (leider keine genaue Zeitangabe) durchgeführt, der aber keine signifikanten Veränderungen aufzuweisen hatte. Daraus schlossen die Autoren, dass Ganoderma keine unkontrollierten Hemmungen der Thrombozytenaggregation ausführt und dadurch zu einer erhöhten Blutungsneigung führt.
In einer randomisierten, doppelblinden, Placebo kontrollierten Studie (A prospective, randomized, double-blind, placebo-controlled study of the platelet and global hemostatic effects of Ganoderma lucidum (Ling-Zhi) in healthy volunteers.) mit insgesamt 40 gesunden Probanden konnte diese Beobachtung bestätigt werden. Gerinnungsfaktoren und Thrombozytenaggregation waren bei Verum- und Plazebogruppe vergleichbar. Daher schlossen die Autoren, dass der Verzehr von Ganoderma vor einer Operation für sonst gesunde Menschen kein Risiko für eine erhöhte Blutungsneigung darstellt.
Neben den weiteren naturheilkundlichen Alternativen einer Prävention gibt es noch ganz allgemeine Möglichkeiten, eine Thrombose zu verhindern. Die Wichtigste davon ist Bewegung. Oder mit anderen Worten: Bewegungslosigkeit ist maßgeblich an der Entstehung von Thrombosen beteiligt. Bei einem erhöhten Risiko kann der Betroffene prophylaktisch Kompressionsstrümpfe tragen.
Fast banal (und eigentlich selbstverständlich) mag der letzte Hinweis auf eine effektive Prophylaxe klingen: viel Wasser trinken. Denn Flüssigkeitsverlust „dickt“ das Blut ein und es kommt zu einer höheren Viskosität, was, wie weiter oben beschrieben, zu einer Erhöhung der Thromboseneigung führen kann. Ebenso spielt meiner Erfahrung das Thema Übersäuerung eine sehr wichtige Rolle. In der Dunkelfeldmikroskopie ist dieses Phänomen sehr gut zu beobachten:
Abb. 2: Hier sehen Sie ein Blutbild (Dunkelfeldmikroskopie) eines Patienten, bei dem wir den Befund einer “Übersäuerung” stellen können. Die weißen “Scheiben” sind rote Blutkörperchen. Die kleinen weißen “Striche”, die sich zusammengelagert haben, deuten die Übersäuerung an. Vor allem, wenn sich diese Filite (nach Enderlein), relativ rasch nach der Blutentnahme entwickeln. Bildquelle: dunkelfeld – uebersaeuerung
Behandlung & Therapie
Cumarin-Derivate, Vitamin-K-Antagonisten und andere Antikoagulantien kommen oral zum Einsatz, während man Heparin nur intravenös applizieren kann. Bei beiden Formen, oral oder intravenös, besteht immer eine ausgeprägte Neigung zu Blutungen. Von daher ist das Monitoring des sogenannten Quick-Werts notwendig. Denn zu wenig Antikoagulantien lässt die Thromboseneigung steigen, zu viel des Guten lässt die Blutungsneigung steigen.
Bewegung ist eine gute Therapie und eine noch bessere Prophylaxe. Daher werden Patienten mit Thrombosen nicht mehr ans „Bett gefesselt“, sondern mobilisiert so gut es eben geht. Begleitend dazu kommen Kompressionsstrümpfe oder -verbände zum Einsatz, um eine Stase zu verhindern. Denn die Kompression beschleunigt den Blutfluss in den tiefen Venen und verhindert eine Umverteilung des Blutes in die mehr an der Oberfläche gelegenen Venen. Dort, wo keine Kompression möglich ist, zum Beispiel bei einer Beckenvenenthrombose, ist eine stationäre Behandlung fast unumgänglich. Beinvenenthrombosen und Beckenvenenthrombosen sind oft schmerzhaft, so dass auch eine Mobilisierung nur eingeschränkt möglich ist.
Naturheilkunde, Alternativmedizin & Hausmittel
Im Folgenden finden Sie einige weitere naturheilkundliche und Alternative Therapieverfahren, die bei einer Thrombose in Frage kommen können.
Eine sofortige Umstellung der Essgewohnheiten ist für mich hier unerlässlich:
vor allem Eiweiß und Fett müssen reduziert werden. Vermeiden Sie vor allem Schweinefleisch (Würste). Essen Sie viel Gemüse, Obst und nur gesundes, biologisches Fleisch.
Fette: vermeiden Sie gesättigte Fette, Transfettsäuren und oxydierte Fette. Pommes Frites, Bratkartoffeln, Margarine, Gegrilltes und stark Gebratenes und vor allem die sog. “Teilchen” oder “Stückchen” (ebenso Croissants) vom Bäcker! Diese triefen vor oxidierten Fetten.
Reduzieren Sie auch die einfachen Kohlenhydrate, wie Zucker und Weißmehl.
Trinken Sie wenigstens 20ml Wasser pro Kilogramm Körpergewicht, um das Blut immer dünnflüssig zu halten.
Nattokinase scheint einen positiven Einfluss auf die Blutgerinnung zu haben, ist es in der Lage, an verschiedenen Stellen der Gerinnungskette einzugreifen und Thrombozytenaggregationsneigungen herabzusetzen. Von daher scheint es sich als Blutverdünner zu eignen und damit die „tägliche Aspirin-Tablette“ zu ersetzen. Allerdings scheint der Mechanismus umfassender zu sein als der von Aspirin, welches nur die Thrombozytenaggregation hemmt.
Der Säure-Basen-Haushalt und das Thema “Übersäuerung” spielt vor allem bei Thrombosen eine wichtige Rolle.
Inforationsquelle:
Naturheilt: Lexikon der Naturheilkunde und Alternativmedizin
